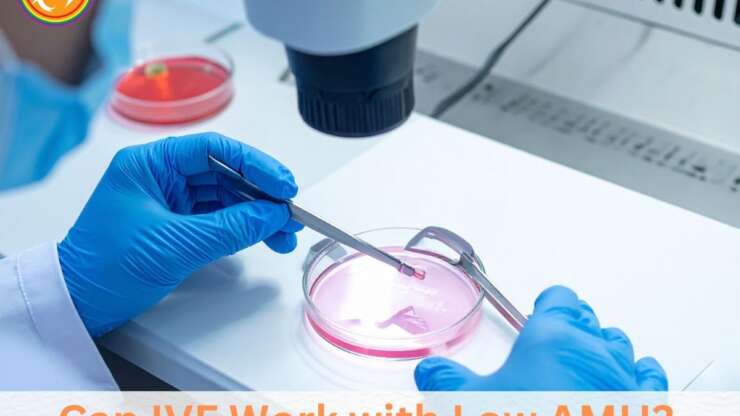
Can IVF Work with Low AMH? Success Rates and Treatment Options

For many individuals and couples struggling with infertility, using a sperm donor can make parenthood possible. The cost of sperm donation varies widely depending on factors such as whether the donor is anonymous or known, if the sperm is purchased from a sperm bank, and whether additional medical or legal services are required. On average, the cost can range from…